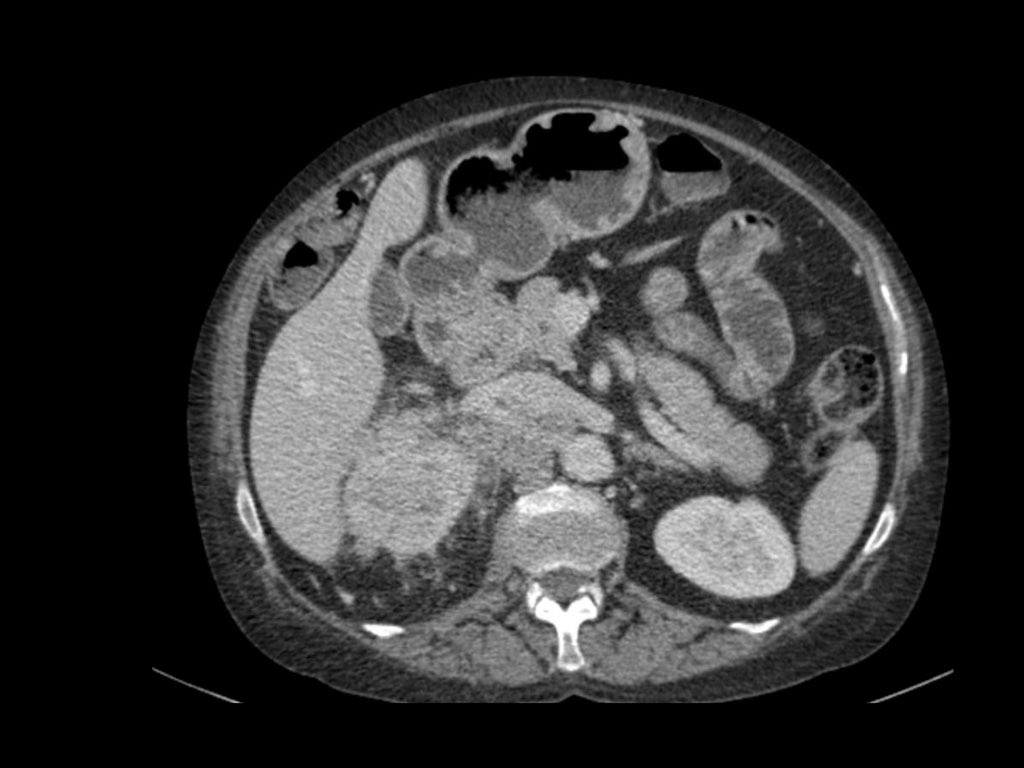
Slider image 9

Khối u đặc thận
Ngày xuất bản
Hầu hết các khối tại thận là những phát hiện tình cờ.
Nhiều trong số các khối này là ung thư biểu mô tế bào thận.
Mục tiêu của chẩn đoán hình ảnh là phân biệt các ung thư biểu mô tế bào thận này với các bệnh lý lành tính, mặc dù trong nhiều trường hợp điều này có thể không thực hiện được.
Tuy nhiên, có một số đặc điểm hình ảnh gợi ý bệnh lý lành tính hoặc ác tính độ thấp.
Các đặc điểm hình ảnh này có thể cung cấp định hướng cho bệnh nhân và bác sĩ lâm sàng trong việc đưa ra quyết định xử trí. Các lựa chọn bao gồm cắt thận bán phần hoặc toàn phần, sinh thiết, đốt khối u hoặc theo dõi định kỳ.
Trong bài viết này, chúng tôi sẽ thảo luận về các đặc điểm hình ảnh của các khối u thận lành tính, ác tính và các tổn thương giả u tại thận.
Chẩn đoán phân biệt các khối thận
Các bước trong chẩn đoán phân biệt một tổn thương thận bao gồm:
- Đầu tiên, xác định xem tổn thương có phải là nang hay không.
- Nếu không phải nang, tìm kiếm mỡ đại thể, đây là dấu hiệu của u mỡ cơ mạch (AML) lành tính.
- Loại trừ các bệnh lý giả u như nhiễm trùng và nhồi máu, thường biểu hiện trong các bối cảnh lâm sàng khác nhau.
- Loại trừ bệnh di căn và u lympho; các tổn thương khu trú tại thận thường chỉ gặp trong bệnh lý lan rộng.
Sau khi thực hiện các bước trên, sẽ có nhiều trường hợp không thể đưa ra chẩn đoán xác định và ung thư biểu mô tế bào thận vẫn đứng đầu danh sách chẩn đoán phân biệt.
Sử dụng CT và MRI để tìm kiếm các dấu hiệu gợi ý u lành tính hoặc u độ thấp so với ung thư biểu mô tế bào thận độ cao.
CT
Tăng tỷ trọng trên CT không tiêm thuốc cản quang
Tổn thương có tỷ trọng > 70 HU trên CT không tiêm thuốc cản quang là nang xuất huyết.
Nang xuất huyết có thể có tỷ trọng thấp hơn 70 HU, nhưng trong những trường hợp này cũng cần kiểm tra chuỗi hình ảnh sau tiêm thuốc cản quang để đánh giá sự ngấm thuốc.
Không có ngấm thuốc xác nhận bản chất dạng nang của các tổn thương này.
Mỡ đại thể < -20 HU trong một khối thận là dấu hiệu đáng tin cậy của u mỡ cơ mạch.
Các lát cắt mỏng có thể hữu ích trong việc xác định tỷ trọng.
Đáng tiếc là 5% các AML không chứa mỡ đại thể.
Các AML nghèo lipid này không thể phân biệt được với ung thư biểu mô tế bào thận.
Trong một số trường hợp hiếm gặp, ung thư biểu mô tế bào thận (RCC) cũng có thể chứa mỡ.
Sự hiện diện đồng thời của vôi hóa và mỡ cần làm tăng nghi ngờ về RCC.
Ngấm thuốc không rõ ràng từ 10-20 HU có thể do hiện tượng giả ngấm thuốc trong nang, là hệ quả của xảo ảnh làm cứng chùm tia.
MRI có thể hữu ích trong việc phân biệt các trường hợp này, vì MRI thể hiện sự ngấm thuốc tốt hơn.
Ngấm thuốc không rõ ràng cũng có thể gặp trong các tổn thương ngấm thuốc yếu như ung thư biểu mô tế bào thận dạng nhú, thường là phân nhóm ít xâm lấn hơn so với ung thư biểu mô tế bào sáng phổ biến hơn.
Ngấm thuốc đồng nhất và giá trị tỷ trọng cao trên CT không tiêm thuốc cản quang (> 40 HU) gợi ý chẩn đoán AML nghèo lipid, mặc dù không thể loại trừ hoàn toàn RCC.
Ngấm thuốc mạnh được gặp trong ung thư biểu mô tế bào sáng, AML nghèo lipid và u tế bào ưa axit (oncocytoma).
Do ung thư biểu mô tế bào sáng phổ biến hơn nhiều so với oncocytoma hoặc AML nghèo lipid, ung thư biểu mô tế bào sáng là chẩn đoán có khả năng nhất, đặc biệt trong trường hợp khối lớn và không đồng nhất.
Cần đề cập khả năng AML nghèo lipid hoặc oncocytoma trong báo cáo, vì theo dõi hoặc sinh thiết có thể là lựa chọn phù hợp cho các bệnh nhân có nguy cơ phẫu thuật cao.
MRI
Tăng tín hiệu trên chuỗi xung T1W thường gặp trong nang xuất huyết hoặc nang chứa protein và trong u mỡ cơ mạch có chứa mỡ ngoại bào đại thể.
Tuy nhiên, mỡ nội bào không tạo ra tăng tín hiệu trên chuỗi xung T1W mà gây ra hiện tượng giảm tín hiệu trên ảnh lệch pha (out of phase).
Điều này có thể gặp trong AML ít mỡ hoặc RCC.
82% RCC tế bào sáng có chứa mỡ nội bào, với độ đặc hiệu 90% cho chẩn đoán ung thư biểu mô tế bào thận dạng tế bào sáng.
MRI vượt trội hơn CT trong chẩn đoán chính xác tổn thương dạng nang, đồng thời thể hiện sự ngấm thuốc tốt hơn và phân biệt được hiện tượng giả ngấm thuốc trên CT với ngấm thuốc thực sự.
Giảm tín hiệu T2W gợi ý RCC dạng nhú hoặc u mỡ cơ mạch ít mỡ.
Tăng tín hiệu T2W thường gặp trong RCC tế bào sáng nhưng không đặc hiệu, vì cũng có thể gặp trong oncocytoma.
Như vậy, vẫn còn nhiều sự chồng lấp đáng kể giữa u lành tính và u ác tính.
Dạng cầu hay dạng hạt đậu
Một cách tiếp cận khác để đánh giá các khối đặc tại thận là dựa vào hình dạng.
Các tổn thương đặc có thể được phân loại thành tổn thương dạng cầu và tổn thương dạng hạt đậu.
Tổn thương dạng cầu là loại phổ biến nhất, biểu hiện là các khối phát triển bành trướng, làm biến dạng bờ thận.
Ung thư biểu mô tế bào thận và oncocytoma là các tổn thương điển hình dạng cầu.
Tổn thương dạng hạt đậu không làm biến dạng bờ thận và hình dạng hạt đậu của thận vẫn được bảo tồn.
Tổn thương dạng hạt đậu khó phát hiện hơn và thường không nhìn thấy trên CT không tiêm thuốc cản quang.
Cần lưu ý rằng có sự chồng lấp đáng kể trong chẩn đoán phân biệt giữa tổn thương dạng cầu và tổn thương dạng hạt đậu.
Tổn thương dạng hạt đậu
Các đặc điểm hình ảnh của tổn thương dạng hạt đậu thường không đặc hiệu.
Lưu ý sự tương đồng về hình ảnh của các tổn thương trong hình.
Chẩn đoán phân biệt thường có thể được gợi ý bằng cách tích hợp dữ liệu lâm sàng và hình ảnh.
- Tổn thương thâm nhiễm trung tâm lấp đầy bể thận ở bệnh nhân lớn tuổi nhiều khả năng là ung thư biểu mô tế bào chuyển tiếp (TCC), còn gọi là ung thư biểu mô tế bào niệu mạc (UCC).
- Khối thâm nhiễm ở bệnh nhân trẻ có đặc điểm hồng cầu hình liềm nhiều khả năng là ung thư biểu mô tủy thận.
- Tổn thương đa ổ và hai bên hoặc thâm nhiễm thận lan tỏa kết hợp với hạch bạch huyết to và tổn thương các cơ quan khác gợi ý u lympho.
- Tổn thương thận đa ổ và hai bên trong bệnh ác tính đã biết gợi ý di căn, mặc dù trong trường hợp một khối thâm nhiễm đơn độc, cần xem xét ung thư biểu mô tế bào thận thể thâm nhiễm.
- Ở bệnh nhân có đau và dấu hiệu nhiễm trùng, chẩn đoán là viêm thận bể thận.
- Tổn thương hình nêm gợi ý nhồi máu thận.
Kích thước khối u
Kích thước khối u được coi là yếu tố dự báo quan trọng nhất về tính ác tính và độ mô học xâm lấn (1).
Nguy cơ bệnh di căn phụ thuộc vào kích thước khối u.
Nếu kích thước khối u nhỏ hơn 3 cm, nguy cơ bệnh di căn là không đáng kể.
Hầu hết các khối thận được phát hiện tình cờ đều nhỏ, được định nghĩa là < 4 cm.
Nhiều trong số các khối này sẽ là RCC độ thấp, bệnh ác tính tiến triển chậm hoặc tổn thương lành tính.
Trong các khối thận từ 1-2 cm được phẫu thuật cắt bỏ, 56% có mô học lành tính. Chỉ 13% các khối từ 6-7 cm có mô học lành tính.
Tuy nhiên, tốc độ tăng trưởng của khối thận nhỏ trên hình ảnh theo dõi nối tiếp chưa được chứng minh là cung cấp dự báo đáng tin cậy về tính ác tính hay lành tính.
Ung thư biểu mô tế bào thận
Ung thư biểu mô tế bào thận (RCC) là tổn thương điển hình dạng hình cầu.
50% các trường hợp RCC được phát hiện tình cờ trên các phương tiện chẩn đoán hình ảnh thực hiện vì các triệu chứng không liên quan đến đường tiết niệu.
Đỉnh tần suất mắc RCC là trong độ tuổi từ 60 đến 70.
RCC có liên quan đến các hội chứng di truyền như von Hippel-Lindau, xơ cứng củ (tuberous sclerosis) và Birt-Hogg-Dubé.
Phân nhóm mô học phổ biến nhất của RCC là ung thư biểu mô tế bào sáng (clear cell carcinoma), tiếp theo là RCC dạng nhú (papillary) và RCC tế bào ưa sắc (chromophobe).
RCC dạng nang đa thùy (multilocular cystic RCC) ít gặp và được thảo luận tại đây.
Ung thư biểu mô tủy thận (renal medullary carcinoma) cũng rất hiếm gặp và hầu như chỉ xảy ra ở bệnh nhân mang đặc điểm hồng cầu hình liềm (sickle cell trait).
RCC tế bào sáng (Clearcell RCC)
Đây là phân nhóm mô học phổ biến nhất của RCC, chiếm 70% tổng số các trường hợp RCC.
Các khối u này xuất phát từ vỏ thận và thường có xu hướng phát triển bành trướng.
Đây là tổn thương tăng sinh mạch máu (hypervascular), thường không đồng nhất do hoại tử, xuất huyết, thành phần nang hoặc vôi hóa.
Trong một số ít trường hợp, RCC cũng có thể chứa mỡ ngoại bào.
Khi gặp một khối có cả vôi hóa lẫn mỡ, cần cân nhắc khả năng là RCC.
Đặc điểm điển hình của ung thư biểu mô tế bào sáng là ngấm thuốc mạnh trong thì vỏ-tủy (corticomedullary phase).
Điều này có thể khó đánh giá khi tổn thương nhỏ và nằm ở vỏ thận, vốn cũng ngấm thuốc mạnh.
Do đó, thì thận (nephrogenic phase) là thì nhạy cảm nhất để phát hiện các tổn thương này, vì nhu mô thận ngấm thuốc đồng nhất và đậm hơn so với khối u (hình minh họa).
Trên MRI, RCC tế bào sáng thường đồng tín hiệu đến giảm tín hiệu trên chuỗi xung T1W và tăng tín hiệu trên chuỗi xung T2W.
Điển hình là ung thư biểu mô tế bào thận không chứa mỡ ngoại bào, đặc điểm này giúp phân biệt với u mỡ cơ mạch (angiomyolipoma).
Tuy nhiên, 80% RCC tế bào sáng có chứa mỡ nội bào, dẫn đến hiện tượng giảm tín hiệu trên ảnh T1W pha đối (opposed-phase) so với ảnh pha đồng (in-phase).
Không được nhầm lẫn dấu hiệu này với mỡ ngoại bào và không được kết luận sai rằng đây là u mỡ cơ mạch.
Bệnh von Hippel-Lindau có liên quan đến sự phát triển của RCC tế bào sáng, thường hai bên hoặc đa ổ.
Bệnh nhân mắc RCC tế bào sáng có tỷ lệ sống sót 5 năm là 50-60%, tiên lượng kém hơn so với RCC dạng nhú hoặc RCC tế bào ưa sắc.

Tổn thương thâm nhiễm ở cực trên thận phải, hầu như không thấy trên ảnh không tiêm thuốc (bên trái), thấy rõ ràng ở thì thận (bên phải). Giải phẫu bệnh xác nhận RCC tế bào sáng
Trong số tất cả các RCC tế bào sáng, khoảng 5% có kiểu tăng trưởng thâm nhiễm.
Mặc dù đây chỉ là một tỷ lệ nhỏ trong số các RCC, nhưng tần suất chung của RCC khiến đây trở thành một chẩn đoán phân biệt quan trọng đối với tổn thương thâm nhiễm dạng hình đậu (bean-type).
RCC thâm nhiễm có tính chất xâm lấn cao và tăng sinh mạch máu.
Tổn thương làm thay đổi cấu trúc nội tại của thận nhưng vẫn bảo tồn đường bờ thận. Các bất thường hệ thống đài bể thận có thể tương tự như những gì thấy trong ung thư biểu mô tế bào chuyển tiếp (transitional cell carcinoma).
RCC dạng nhú (Papillary RCC)
RCC dạng nhú chiếm 10-15% tổng số các trường hợp RCC.
Các tổn thương này thường đồng nhất và ít mạch máu (hypovascular), do đó có thể bắt chước hình ảnh nang thận.
Trái ngược với ung thư biểu mô tế bào sáng, mức độ ngấm thuốc của RCC dạng nhú có thể rất kín đáo, chỉ chênh lệch 10-20 HU giữa ảnh không tiêm và có tiêm thuốc cản quang.
RCC dạng nhú kích thước lớn có thể không đồng nhất hơn do hoại tử, xuất huyết hoặc vôi hóa.
Trên MRI, các tổn thương này thường đồng tín hiệu đến giảm tín hiệu trên chuỗi xung T1W và giảm tín hiệu trên chuỗi xung T2W.
Trong những trường hợp rất hiếm gặp, có thể thấy mỡ đại thể trong tổn thương, thường kèm theo vôi hóa.
Khối u hai bên và đa ổ gặp nhiều hơn trong RCC dạng nhú so với các loại RCC khác.
Tỷ lệ sống sót 5 năm là 80-90%.
RCC tế bào ưa sắc (Chromophobe RCC)
5% các trường hợp RCC thuộc loại tế bào ưa sắc.
Đây là tổn thương đặc, bờ rõ và đôi khi hơi có múi.
Tổn thương có thể có sẹo trung tâm hoặc kiểu ngấm thuốc dạng nan hoa (spoke-wheel pattern), tương tự như u tế bào ưa axit (oncocytoma).
Không thể phân biệt RCC tế bào ưa sắc với u tế bào ưa axit trên hình ảnh học.
Ngay cả mô học của hai loại u này cũng có những đặc điểm tương đồng.
Mức độ ngấm thuốc của RCC tế bào ưa sắc thường đồng nhất và kém đậm hơn so với RCC tế bào sáng.
Tiên lượng của RCC tế bào ưa sắc tương tự như RCC dạng nhú với tỷ lệ sống sót 5 năm là 80-90%.
RCC tế bào ưa sắc có thể gặp ở bệnh nhân mắc hội chứng Birt-Hogg-Dubé.
Hội chứng Birt-Hogg-Dubé là một rối loạn hiếm gặp.
Những bệnh nhân này có các tổn thương da dạng sẩn nhỏ gọi là u nang nang lông (fibrofolliculomas), nang phổi kèm tràn khí màng phổi tự phát và tần suất cao mắc các loại ung thư biểu mô tế bào thận khác nhau: thường gặp nhất là RCC tế bào ưa sắc, ít gặp hơn là u tế bào ưa axit (oncocytoma), và hiếm gặp là ung thư biểu mô tế bào sáng.
Phân giai đoạn RCC
RCC có thể xâm lấn mỡ quanh thận vượt qua cân thận và có thể lan vào tĩnh mạch thận, tĩnh mạch chủ dưới (IVC) hoặc tuyến thượng thận cùng bên.
Đối với phẫu thuật viên, điều quan trọng là cần biết có huyết khối u trong IVC hay không và liệu huyết khối có lan vào lồng ngực trên cơ hoành hay không (cần có phẫu thuật viên lồng ngực trong ca mổ).
Khoảng 25% bệnh nhân đã có di căn tại thời điểm chẩn đoán.
U tế bào ưa axit (Oncocytoma)
Oncocytoma là khối đặc lành tính ở thận phổ biến thứ hai.
3-7% tổng số khối u thận đặc là oncocytoma.
Trên CT, các khối u này biểu hiện là các tổn thương có ranh giới rõ nét, ngấm thuốc đồng nhất và thường có sẹo trung tâm.
Sẹo trung tâm không thể phân biệt được với sẹo trung tâm hoặc hoại tử trung tâm trong ung thư biểu mô tế bào thận (RCC), do đó oncocytoma là khối đặc lành tính được phẫu thuật cắt bỏ thường gặp nhất.
Vôi hóa trong oncocytoma là hiếm gặp.
Khối u thường đơn độc, đường kính 2-12 cm, nhưng có thể xuất hiện đa ổ và hai bên.
Trong ít hơn 10% các trường hợp, oncocytoma và ung thư biểu mô tế bào thận thể tế bào ưa sắc (chromophobe RCC) xuất hiện đồng thời.
Ung thư biểu mô tế bào chuyển tiếp
Ung thư biểu mô tế bào chuyển tiếp (TCC), còn được gọi là ung thư biểu mô tế bào niệu mạc (UCC), xuất phát từ các tế bào biểu mô lót đường tiết niệu.
TCC thường gặp nhất ở bể thận, dưới dạng khối u bề mặt độ thấp, tạo thành một khối trong lòng khu trú tại hệ thống đài bể thận.
Khoảng 15% các trường hợp TCC thuộc loại xâm lấn hơn với kiểu phát triển thâm nhiễm, làm thay đổi cấu trúc vùng của xoang thận và nhu mô thận lân cận, nhưng không làm thay đổi đường bờ thận.
TCC là tổn thương điển hình dạng hạt đậu (xem hình).
TCC đường tiết niệu trên có đỉnh tần suất ở nhóm tuổi 60–70 và gặp ở nam giới nhiều gấp đôi so với nữ giới.
Các yếu tố nguy cơ bao gồm hút thuốc lá, tiếp xúc với chất gây ung thư hóa học, điều trị bằng cyclophosphamide và lạm dụng thuốc giảm đau, đặc biệt là sử dụng phenacetin kéo dài.
TCC khó phát hiện trên hình ảnh CT không tiêm thuốc cản quang.
Thì thận sinh (nephrogenic phase) là thì tối ưu để thấy rõ ranh giới giữa TCC và nhu mô thận bình thường có ngấm thuốc.
Hình ảnh thì bài tiết cho thấy các bất thường của hệ thống đài bể thận như đài thận giãn, đài thận bị khối u lấp đầy hoặc đài thận không ngấm thuốc do khối u thâm nhiễm.
TCC có thể xâm lấn tại chỗ vào khoang sau phúc mạc. Có thể gặp hạch bạch huyết vùng và di căn xa đến phổi và xương.
TCC thường có tính chất đa ổ với tỷ lệ tái phát cao, do đó đòi hỏi phải theo dõi chặt chẽ và toàn diện.
TCC có nguy cơ gieo rắc tế bào ung thư sau sinh thiết qua da cao hơn so với ung thư biểu mô tế bào thận (RCC), do đó không khuyến cáo thực hiện sinh thiết khi nghi ngờ TCC.
U lympho
Thận là vị trí ngoài hạch thường gặp trong bệnh u lympho, đặc biệt là u lympho không Hodgkin.
Tổn thương nguyên phát tại thận là hiếm gặp.
U lympho thận thường biểu hiện dưới dạng nhiều khối ngấm thuốc kém, nhưng cũng có thể biểu hiện dưới dạng khối u sau phúc mạc xâm lấn trực tiếp vào thận hoặc các khối phần mềm quanh thận.
Thâm nhiễm lan tỏa vào mô kẽ thận dẫn đến thận to và gặp nhiều hơn trong u lympho Burkitt.
Hình ảnh cho thấy tổn thương thận hai bên và tổn thương xương ở bệnh nhân u lympho tế bào B.
Đây là một bệnh nhân khác với u lympho khu trú tại trung thất, tụy (mũi tên) và cả hai thận.
Hình ảnh phì đại lan tỏa cả hai thận ở bệnh nhân u lympho.
Tiếp tục xem hình PET-CT.
PET-CT cho thấy tổn thương thận lan tỏa và các hạch bạch huyết cạnh động mạch chủ dương tính (mũi tên).
Di căn

Tổn thương xâm lấn ở cực dưới thận phải, phát triển đáng kể sau sáu tháng, kèm theo hạch bạch huyết lan rộng. Đây được xác định là di căn của ung thư phổi.
Các khối u ác tính nguyên phát thường di căn đến thận nhất bao gồm ung thư phổi, ung thư vú, các khối u đường tiêu hóa và u hắc tố (melanoma).
Di căn thận thường xuất hiện muộn trong tiến trình của một bệnh ác tính đã biết, như một phần của bệnh lan rộng toàn thân.
Trong một số ít trường hợp, di căn thận có thể biểu hiện dưới dạng một tổn thương đơn độc và khó phân biệt với ung thư biểu mô tế bào thận.
Sinh thiết qua da có thể được thực hiện để giải quyết vấn đề này.
Di căn thận thường có kích thước nhỏ, đa ổ và hai bên, với hình thái phát triển xâm lấn.
Các tổn thương này ngấm thuốc nhẹ, kém hơn nhiều so với nhu mô thận bình thường.
Tuy nhiên, di căn cũng có thể tăng sinh mạch máu, như trong trường hợp u hắc tố và đôi khi là ung thư vú.
Hình ảnh cho thấy bệnh nhân có nhiều tổn thương di căn thận.
Lưu ý huyết khối khối u trong tĩnh mạch thận trái.
Đây là hình ảnh của một bệnh nhân ung thư phổi.
Có một tổn thương di căn ở thận trái và nhiều tổn thương di căn hạch bạch huyết (mũi tên).
Nếu đây là biểu hiện duy nhất, sẽ rất khó để phân biệt với ung thư biểu mô tế bào thận có di căn hạch bạch huyết.
Nhiễm trùng
Viêm bể thận và áp xe thận có thể bắt chước hình ảnh khối u, tuy nhiên trong hầu hết các trường hợp, bệnh sử và các dấu hiệu lâm sàng sẽ giúp đưa ra chẩn đoán chính xác.
Trong trường hợp này, có các vùng giảm tỷ trọng ở cả hai thận.
Chỉ dựa trên hình ảnh, chẩn đoán phân biệt chính bao gồm viêm bể thận đa ổ, u lympho và di căn.
Bệnh nhân này có tiền sử nhiễm trùng đường tiết niệu, các đợt đau hông lưng và không có tiền sử u nguyên phát hay u lympho.
Do đó, chẩn đoán là viêm bể thận.
Chụp CT 4 tháng sau cho thấy sự ngấm thuốc bình thường của cả hai thận; các bất thường thận trên lần chụp đầu tiên do đó phù hợp với một đợt viêm bể thận đa ổ.
Áp xe thận thường là biến chứng của viêm bể thận cấp tính, bệnh nhân biểu hiện với nhiễm trùng đường tiết niệu, đau hông lưng và sốt.
Trên CT, áp xe thận thường biểu hiện là một tổn thương giảm tỷ trọng đồng nhất không đặc hiệu hoặc là một tổn thương dạng nang phức tạp.
Áp xe thận có thể có thành dày, không đều, ngấm thuốc kèm xâm lấn mỡ quanh thận (hình).
Ở những bệnh nhân có biểu hiện lâm sàng không điển hình, hình ảnh nang phức tạp và lan rộng vào mỡ quanh thận có thể mô phỏng ung thư biểu mô tế bào thận.
Bệnh nhân này có biểu hiện điển hình với đau hông lưng phải và các kết quả xét nghiệm phù hợp với nhiễm trùng đường tiết niệu.
Hình ảnh siêu âm cho thấy một tổn thương giảm âm với một số vùng trống âm, gợi ý thành phần chứa dịch bên trong.
Tổn thương này được xác định là áp xe.
Viêm bể thận u hạt vàng (Xanthogranulomatous pyelonephritis)
Viêm bể thận u hạt vàng là một tình trạng hiếm gặp, do nhiễm trùng u hạt mạn tính với sự tích tụ của các đại thực bào chứa lipid.
Thường có sỏi gây tắc nghẽn kèm giãn đài thận.
Bệnh dẫn đến phá hủy thận lan tỏa, nhưng cũng có thể khu trú theo từng phân đoạn.
Thận to gặp ở tất cả bệnh nhân và trong một số trường hợp có thể thấy mỡ đại thể.
Đây là một ví dụ khác về viêm bể thận u hạt vàng.
Có hình ảnh phá hủy thận phải, nhiều sỏi và tăng sinh mô xơ mỡ xung quanh.
Hình ảnh này có thể giống với u mỡ xơ ác tính (liposarcoma).
Nhồi máu
Nhồi máu thận thường là hậu quả của thuyên tắc huyết khối trong bệnh lý tim mạch.
Biểu hiện lâm sàng thường gặp là đau hông lưng cấp tính và đái máu.
Trong giai đoạn cấp, CT sẽ cho thấy một vùng giảm tỷ trọng hình nêm, tiếp theo là teo thận ở giai đoạn muộn hơn.
Khi toàn bộ thận bị nhồi máu, thận sẽ to ra và có tỷ trọng thấp.
Chỉ có lớp vỏ ngoài có thể vẫn còn ngấm thuốc qua các mạch bàng hệ, tạo ra dấu hiệu viền vỏ thận (cortical rim sign).
Đây là một trường hợp nhồi máu thận khác.
Nhồi máu thận phải và lách ở bệnh nhân có thuyên tắc mạch hệ thống đa ổ.
Lưu ý và Bẫy chẩn đoán
Ngấm thuốc giả (Pseudo-enhancement)
Ngấm thuốc giả là một bẫy chẩn đoán cần lưu ý khi đánh giá các khối thận.
Như đã đề cập, một sự chênh lệch nhỏ về đơn vị Hounsfield (< 20 HU) có thể được đo trong một nang thận trên hình ảnh CT có thuốc cản quang do hiện tượng làm cứng chùm tia (beam-hardening).
Trường hợp này minh họa hiện tượng ngấm thuốc giả trong một tổn thương, được xác nhận là nang thận trên MRI.
Bướu lạc đà (Dromedary hump)
Cột Bertin nổi bật, sự phồng lồi bờ viền thận và phì đại thận khu trú có thể trông giống như một khối thận trên siêu âm, hình ảnh không tiêm thuốc cản quang và CT ở thì thận (nephrogenic phase).
Ở thì vỏ-tủy (corticomedullary phase), cấu trúc vỏ-tủy bình thường trong các giả u này có thể được nhận diện rõ ràng, giúp phân biệt chúng với các tổn thương thực sự.
Nghi ngờ khối thận ở thận trái trên siêu âm.
CT cho thấy hình ảnh phồng lồi bờ viền thận trái, thường được gọi là “bướu lạc đà” (dromedary hump).

Giả u (Pseudotumor). Thì thận (Nephrogenic phase) ở bên trái và thì vỏ-tủy (Corticomedullary phase) ở bên phải.
Đây là một trường hợp khác.
Ở thì thận, có thể đặt ra nghi vấn về sự hiện diện của một tổn thương ở thận trái.
Tuy nhiên, ở thì vỏ-tủy, rõ ràng đây là một giả u (pseudotumor).
Quy trình chụp CT
CT là lựa chọn hàng đầu để đánh giá đặc điểm khối thận và phân giai đoạn.
Quy trình chụp tối thiểu phải bao gồm thì không tiêm thuốc cản quang và thì thận (nephrogenic phase).
Thì vỏ-tủy (corticomedullary phase) từ 25-40 giây sau tiêm thuốc được khuyến cáo mạnh mẽ. Thì này giúp phân biệt khối u với giả u và đánh giá mức độ ngấm thuốc của tổn thương.
Tuy nhiên, trong thì này, một khối u nằm ở tủy thận có thể có cùng tỷ trọng với nhu mô xung quanh (hình minh họa).
Do đó, thì thận (±100 giây sau tiêm thuốc) là thì quan trọng nhất để phát hiện khối u.
Thì này cũng cung cấp thông tin về khả năng xâm lấn mạch máu và huyết khối trong lòng mạch do u.
Thì bài tiết (± 8 phút sau tiêm thuốc) là tùy chọn, nhằm khảo sát hệ thống đài bể thận, niệu quản và bàng quang.
Thì này không cần thiết để đánh giá khối ở vỏ thận, nhưng nên thực hiện nếu ung thư biểu mô tế bào chuyển tiếp (TCC) nằm trong chẩn đoán phân biệt.
Từ thiện
Toàn bộ lợi nhuận từ Radiology Assistant được chuyển đến tổ chức Medical Action Myanmar, do Bác sĩ Nini Tun và Bác sĩ Frank Smithuis (giáo sư tại Đại học Oxford, đồng thời là anh trai của Robin Smithuis) điều hành.
Nhấn vào đây để xem video về Medical Action Myanmar. Nếu bạn thấy Radiology Assistant hữu ích, hãy ủng hộ Medical Action Myanmar bằng một món quà nhỏ.